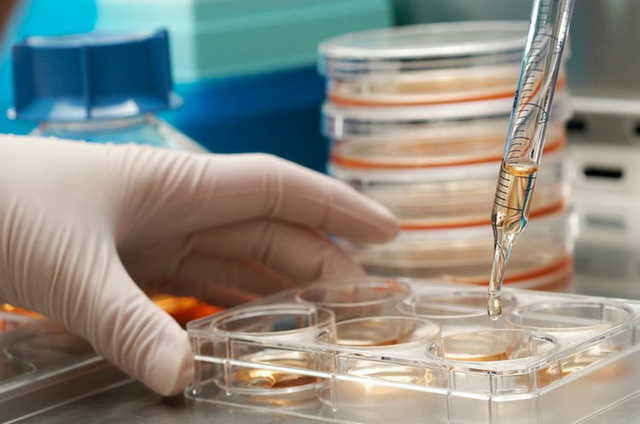
Впервые в истории! В Израиле мужчине вырастили новую ногу из жира

Впервые в истории! В Израиле мужчине вырастили новую ногу из жира
Впервые в истории! В Израиле мужчине вырастили новую ногу из жира
В Израиле стартап Bonus Biogroup разработал способ выращивания в лаборатории костных клеток для пересадки больным с серьезными дефектами костей.
Кость изготовляют из жира пациента, выращивают в течение 2 недель и вводят в область дефекта. За считанные месяцы больные выздоравливают, и у них полностью восстанавливается функциональность, передает isralike.org.
Такой случай произошел с Дани Якобсоном, у которого была раздроблена левая нога. Но после лечения он смог не только ходить без костылей, но и заниматься спортом.

По словам гендиректора компании Bonus Biogroup, доктора Шая Мерецкого, в мире ранее еще никому не удавалось вырастить человеческие ткани вне организма больного. Ожидается, что такой метод лечения будет применяться по всему миру уже через три года.
Теги: РазработкиBonus BiogroupСтартапИзраильМедицина

Комментарии:
comments powered by DisqusЗагрузка...
Наши опросы
Показать результаты опроса
Показать все опросы на сайте












